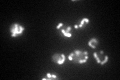
YER141W

View description
Protein required for the hydroxylation of heme O to form heme A, which is an essential prosthetic group for cytochrome c oxidase
Localization:
Intensity:
Fold change:
Significance:
-
C’ GFP library in SD

mitochondria98.56 -
N' NOP1pr-GFP in SD

mitochondria92.3526 -
N' TEF2pr-mCherry in SD

mitochondria140.589 -
N' NATIVEpr-GFP in SD

mitochondria70.4705 -
N' TEF2pr-VC and Cyto-VN in SD

#N/A0 -
C’ GFP library in SD+DTT

mitochondria147.721.49Yes -
C’ GFP library in SD+H2O2

mitochondria117.761.19No -
C’ GFP library in Starvation Media
mitochondria139.861.41Yes -
C’ GFP library on the background of Pup2-DaMP

mitochondria -
C’ GFP library on the background of CCT mutant

mitochondria108.9931.10576No
